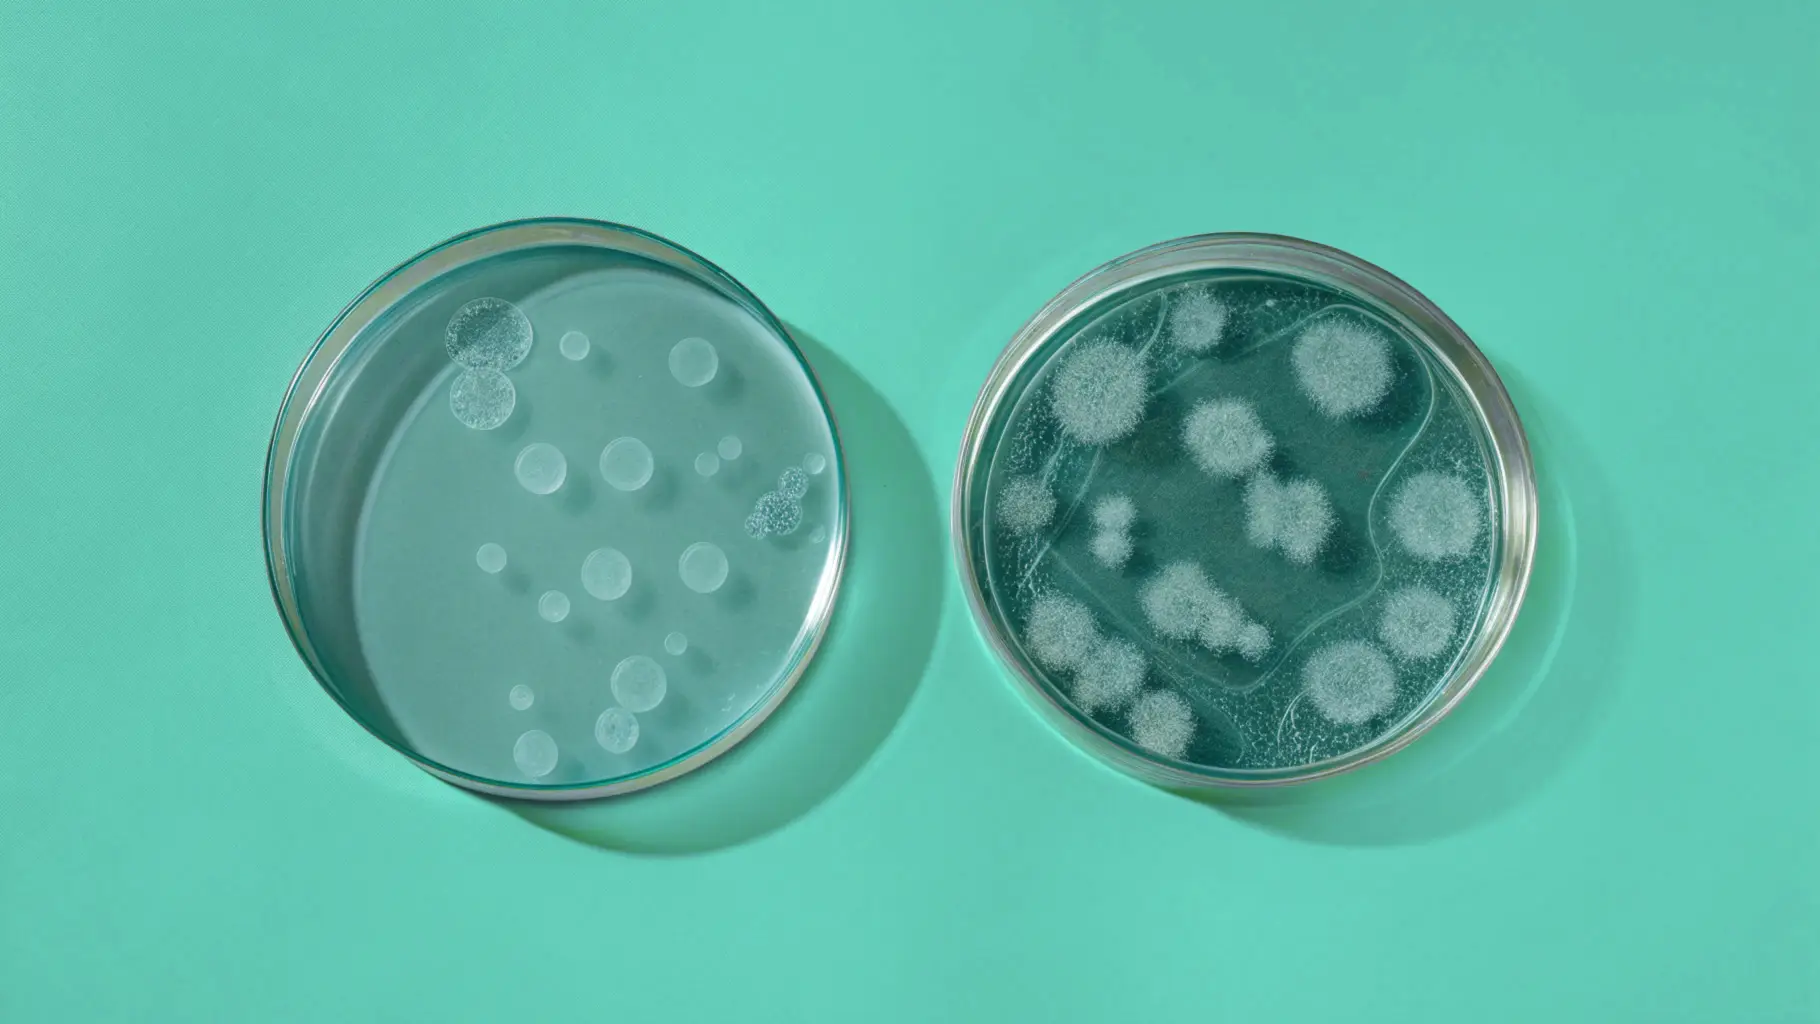

Ensuring the safety of water systems from Legionella bacteria is crucial for public health. Legionella is commonly found in cooling towers, shower areas, spas, and other water systems with stagnant or recirculated water, posing significant health risks. Legionella-proof your watersystem with Anolytech’s solution.

Ensuring the safety of water systems from Legionella bacteria is crucial for public health. Legionella is commonly found in cooling towers, shower areas, spas, and other water systems with stagnant or recirculated water, posing significant health risks. Legionella-proof your watersystem with Anolytech’s solution.


The bacteria spread through aerosolised water droplets, which form when water flows through fixtures like shower heads, faucet aerators, or spa bubbles. Inhaling these tiny droplets allows Legionella to reach the lungs and cause infection.
Legionella thrives in water temperatures between 20°C and 45°C, especially in systems with stagnant water or biofilm buildup. Even if you carefully control water temperatures, biofilm can harbor and protect bacteria, allowing them to persist in the system. Studies have also shown that Legionella can survive at temperatures as high as 70°C when living inside amoebas, making it even harder to eliminate.
Legionella can thrive in various water systems where conditions allow for bacterias to grow. Common risk areas include:

Ensuring bacteria-free water is not just a legal requirement—it is fundamental for the health and safety of anyone using a property or public facility. Whether in residential buildings, hotels, hospitals, or industrial spaces, water quality plays a crucial role in maintaining trust and safeguarding well-being.
Legionella and other harmful bacteria can thrive in poorly maintained water systems, posing serious health risks such as Legionnaires’ disease. For property owners and facility managers, ensuring that water is safe to use and drink is not only a responsibility but also a key component of delivering a safe environment for residents, employees, and visitors.
Being able to guarantee bacteria-free water is a basic requirement in a property or public environment. Visitors and users must feel safe using and drinking the water without the risk of ingesting unhealthy and harmful bacteria.

Anolytech offers an environmentally friendly and highly effective solution to protect your water system from Legionella. Our innovative disinfection system produces AnoDes, a unique pH-optimised hypochlorous acid, directly on-site. By continuously dosing small amounts of AnoDes into the water system, it eliminates harmful bacteria and biofilm while preventing new growth.
With Anolytech’s system, you no longer need to rely on harsh chemicals, costly heating, or frequent system flushes. Anolytech makes it simple and efficient to safeguard your water systems, ensuring bacteria-free water.

Anolytech’s system provides a long-term solution for Legionella prevention by continuously dosing AnoDes into the water system. Unlike many other methods, Anolytech’s solution does not rely on harmful chemicals, making it safe for both humans and the environment. The water remains safe to drink and use during treatment, ensuring uninterrupted use while effectively protecting against bacterial growth.

AnoDes is an environmentally friendly solution produced on-site using only water, salt, and electricity. It’s harmless to both humans and nature, with no harmful by-products, making it a sustainable choice for Legionella control.
Anolytech’s system is approved for use under ECHA regulations and fully complies with the EU Drinking Water Directive. This ensures your water systems meet strict regulatory requirements while maintaining safety and efficiency.

Anolytech’s disinfection system is versatile and designed to work effectively across various water systems, from cooling towers and residential plumbing to maritime environments. With on-site production, it ensures continuous availability and dependable protection against Legionella, no matter the application.

Anolytech’s system is approved for use under ECHA regulations and fully complies with the EU Drinking Water Directive. This ensures your water systems meet strict regulatory requirements while maintaining safety and efficiency.

Anolytech’s disinfection system is versatile and designed to work effectively across various water systems, from cooling towers and residential plumbing to maritime environments. With on-site production, it ensures continuous availability and dependable protection against Legionella, no matter the application.
If you suspect Legionella in your water system, the first and most important step is to test the water. Anolytech offers reliable testing solutions to help you understand the scope of the problem and take appropriate action.
Quick Test
This test provides results in about 25 minutes, displayed directly on a test stick. It’s an ideal solution for obtaining fast answers in vulnerable areas or during specific events. To ensure accuracy, it’s essential to download the corresponding app to interpret the results correctly.
Culture test
This method is performed by an ISO 11731:2017-certified laboratory. It provides highly accurate results and is valid as a certificate according to Swedish regulations. Results are available within two weeks. For establishments required to submit Legionella samples, culture tests are mandatory.

Legionella spreads through aerosolized water droplets, often created by fixtures like showerheads, faucets, or cooling towers. These droplets, when inhaled, allow the bacteria to enter the lungs. Legionella can grow in both hot and cold water systems, for example, when heat transfer from hot water pipes warms nearby cold water pipes. Factors like stagnant water, biofilm buildup, and temperatures between 20°C and 45°C further increase the risk of Legionella proliferation in water systems.
The frequency depends on several factors, including the size and use of the property. For larger buildings with complex water systems, testing may be required multiple times a year. However, we recommend conducting tests at least once annually to ensure safety.
Step 1: Limit the Risk The first step after detecting Legionella is to immediately take action to minimize exposure risk. This might involve temporarily shutting down parts of the water system or implementing strict usage restrictions until further measures can be taken.
Step 2: Take Immediate Action If Legionella levels are very high and need to be reduced quickly, immediate measures such as hot water flushing or shock chlorination may be necessary. These point interventions can help reduce Legionella levels quickly. However, if you don’t change the conditions in your water system - the bacteria will return over time. With Anolytech’s method, you get a permanent solution that guarantees bacteria-free water 24/7 by addressing the root causes of Legionella growth.
Step 3: Implement Preventive Measures After sanitation, it is essential to implement preventive measures to avoid future outbreaks. Anolytech provides a water disinfection solution to ensure your water system remains bacteria-free. Our method not only eliminates existing bacteria but also prevents future growth, offering long-term safety and peace of mind.
Maintaining water temperatures outside Legionella’s growth range (below 20°C or above 50°C) is a common approach but has shown limited effectiveness as a standalone solution. Preventing water stagnation through proper system design and regular use is also critical. For more reliable prevention, Anolytech’s continuous disinfection system uses AnoDes to eliminate bacteria without harmful chemicals, ensuring long-term safety and compliance for your water system.

Particle filter for capturing very small particles down to 1 micron. Used as a pre-filter or control filter...Read More
Particle filter for capturing very small particles down to 1 micron. Used as a pre-filter or control filter in n systems. Extends the lifespan of equipment by reducing particle contamination. Especially suitable for older machines: V2, V2R and V3.
Handheld digital instrument for measuring total chlorine in water (0–5 ppm). Provides accurate and rapid on-site measurements. Requires...Read More
Handheld digital instrument for measuring total chlorine in water (0–5 ppm). Provides accurate and rapid on-site measurements. Requires supplement with liquid reagents. Perfect for routine checks in water treatment facilities.
Liquid reagent for use with Hanna’s measuring instrument for total chlorine. One package contains 300 doses. Essential for...Read More
Liquid reagent for use with Hanna’s measuring instrument for total chlorine. One package contains 300 doses. Essential for performing accurate chlorine measurements in water samples. For professional use in facilities working with water treatment.
Laboratory test according to ISO 11731:2017 for accurate identification of Legionella in drinking water. sample is submitted in...Read More
Laboratory test according to ISO 11731:2017 for accurate identification of Legionella in drinking water. sample is submitted in the included packaging. Provides exact CFU values (colony-forming units). The test must be analyzed within 24 hours of sampling.
Rapid test for Legionella (Ultra One), lateral flow type. Provides results within 25 minutes and is used on-site...Read More
Rapid test for Legionella (Ultra One), lateral flow type. Provides results within 25 minutes and is used on-site in high-risk environments such as showers, cooling towers, water tanks, and pools. Sensitivity: 100 CFU/liter. Shelf life: 18 months from manufacturing date.
Mars 2PC – an effective descaling agent for cleaning the internal parts of the machine. Removes limescale and...Read More
Mars 2PC – an effective descaling agent for cleaning the internal parts of the machine. Removes limescale and extends the lifespan of the equipment. Sold only in cartons of 3 bottles. Suitable for Anolytech's systems and similar dosing equipment.Explore how Anolytech’s innovative solutions have helped businesses across industries achieve bacteria-free water and sustainable operations.
91%
of our customers renew their contracts
500+
hospitals, properties, farms and industries use our solution today
Proven
Thousands of operating hours with customers who demand high water quality
91%
of our customers renew their contracts
500+
hospitals, properties, farms and industries use our solution today
Proven
Thousands of operating hours with customers who demand high water quality
91%
of our customers renew their contracts
500+
hospitals, properties, farms and industries use our solution today
Proven
Thousands of operating hours with customers who demand high water quality








When Anolytech started in 2005, we envisioned creating a sustainable way to make water bacteria-free. Today, our site-produced disinfection system plays a vital role in helping businesses reduce the spread of infection, limit harmful chemicals, and conserve water resources. By switching to Anolytech’s environmentally friendly disinfection method, your business contributes directly to several of the UN’s 17 global goals, including health, environmental sustainability, and climate action.
Anolytech’s solution goes beyond traditional disinfection methods by offering a sustainable, effective, and user-friendly approach. With on-site production of AnoDes, your water system is continuously protected while reducing environmental impact. Discover how our system ensures compliance and reliability for your water treatment needs.
Anolytech’s system provides continuous disinfection by producing AnoDes directly on-site. We offer different systems, each tailored to meet specific customer needs.
AnoDes is a pH-optimized hypochlorous acid, produced on-site using only water, salt, and electricity. AnoDes ensures consistent protection against bacteria, viruses, spores, mold, and fungi, while also preventing the growth of biofilm in water systems.
Anolytech’s system is proudly made in Sweden, ensuring the highest standards of quality, reliability, and innovation. Designed for durability and efficiency, our solution delivers exceptional performance you can trust.
Anolytech’s solution complies with European standards, including multiple EN certifications and approval under the European Chemicals Agency’s (ECHA) Biocidal Products Regulation (Article 95).
Anolytech’s system provides continuous disinfection by producing AnoDes directly on-site. We offer different systems, each tailored to meet specific customer needs.
AnoDes is a pH-optimized hypochlorous acid, produced on-site using only water, salt, and electricity. AnoDes ensures consistent protection against bacteria, viruses, spores, mold, and fungi, while also preventing the growth of biofilm in water systems.
Anolytech’s system is proudly made in Sweden, ensuring the highest standards of quality, reliability, and innovation. Designed for durability and efficiency, our solution delivers exceptional performance you can trust.
Anolytech’s solution complies with European standards, including multiple EN certifications and approval under the European Chemicals Agency’s (ECHA) Biocidal Products Regulation (Article 95).
Fill out the form, and one of our team members will get back to you as soon as possible. We’re happy to assist and would love to discuss how we can help with your disinfection needs—maybe even over a cup of coffee!
Legionella Effective Legionella prevention Ensuring the safety of water systems from Legionella bacteria is crucial for public health. Legionella is commonly found in cooling towers, shower areas, spas, and other […]